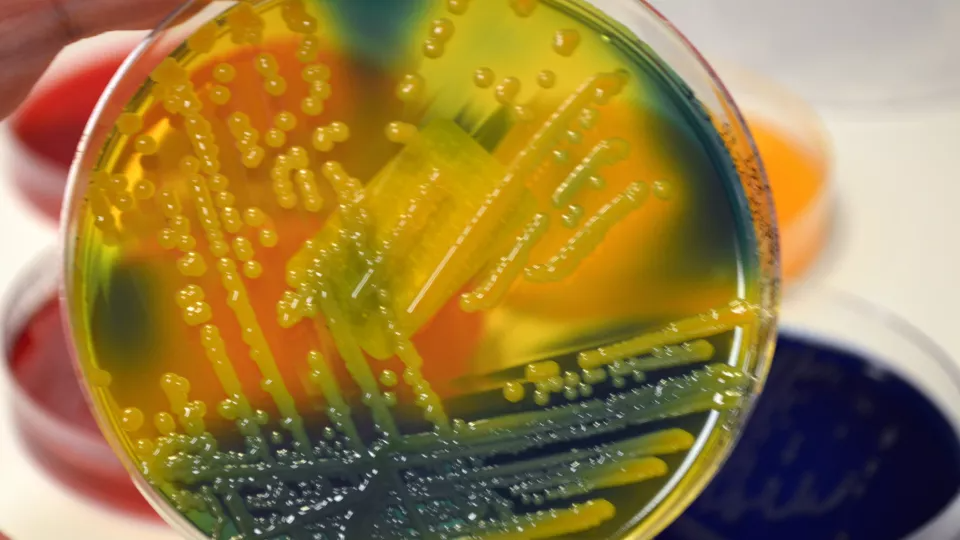

Alarming Antibiotic Resistance Discovered In War-Torn Ukraine
Researchers led by Lund University in Sweden have assisted microbiologists in Ukraine in investigating bacterial resistance among the war-wounded patients treated in hospitals.
Researchers led by Lund University in Sweden have assisted microbiologists in Ukraine in investigating bacterial resistance among the war-wounded patients treated in hospitals. The results, which were recently published in The Lancet Infectious Diseases, reveal that many of the patients were affected by bacteria that exhibited an extremely high level of antibiotic resistance.
Researchers led by Lund University in Sweden have assisted microbiologists in Ukraine in investigating bacterial resistance among the war-wounded patients treated in hospitals. The results, which were recently published in The Lancet Infectious Diseases, reveal that many of the patients were affected by bacteria that exhibited an extremely high level of antibiotic resistance.
“I am quite thick-skinned and have witnessed numerous situations involving patients and bacteria. However, I must admit that I have never encountered bacteria as resistant as this before”, says Kristian Riesbeck, professor of Clinical Bacteriology at Lund University.
There was never any doubt about helping out when Dr. Oleksandr Nazarchuk, a microbiologist at a university in Vinnytsia, Ukraine, got in touch, says Kristian Riesbeck. Help was needed in Ukraine to assess the extent of antibiotic resistance in bacteria among severely injured patients in hospital. In addition to all the human suffering caused by the war in Ukraine, another battle is being fought – an invisible war against resistant bacteria. This became evident when Kristian Riesbeck and his research colleagues analysed patient samples from seriously wounded patients, many of whom had burn injuries, in Ukraine. The patients had acquired infections while in hospital, primarily due to the overwhelmed wards and destroyed infrastructure. Samples were collected from a total of 141 war victims, 133 adults who sustained injures during the war and eight infants diagnosed with pneumonia. These patients were admitted to three different hospitals in Ukraine, where they received emergency surgeries and intensive care to address their conditions. “We observed that several the Gram-negative bacteria exhibited resistance to broad-spectrum antimicrobial agents, including newly developed enzyme-inhibiting antibiotics that are not yet available in the market. Moreover, nearly ten per cent of the samples contained bacteria that demonstrated resistance even to “our last-resort” antibiotic, colistin. While we have encountered similar cases in India and China before, nothing compares to the extent of resistance observed in this study. As much as six per cent of all the samples contained bacteria resistant to every antibiotic we tested,” says Kristian Riesbeck.
He emphasizes that this clearly highlights the challenges posed by resistant bacteria in times of war. In particular, Kristian Riesbeck expresses concern regarding the resistance displayed by Klebsiella pneumoniae bacteria, as they have the potential to cause illness in individuals with a healthy and well-functioning immune system. “This makes me very worried. It’s rare to encounter Klebsiella with such high levels of resistance, and it was not what we anticipated. While isolated cases have been documented in China, the magnitude of this situation surpasses anything we have seen before. While many countries are providing military aid and resources to Ukraine, it is equally crucial to assist them in addressing this ongoing situation. There is an evient risk of further spread of resistant bacteria, and this threatens the entire European region,” remarks Kristian Riesbeck.
Publication: Oskar Ljungquist, et al. Highly multidrug-resistant Gram-negative bacterial infections in war victims in Ukraine. The Lancet Infectious Diseases, (2023). DOI: 10.1016/S1473-3099(23)00291-8
Original Story Source: Lund University

 Alerts Sign-up
Alerts Sign-up